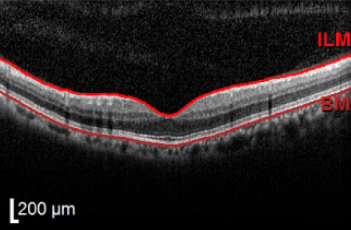

KIM’S RETINA CLINIC
황반변성
김이태 망막 클리닉
시세포들이 밀집되어 있어 주요 시력을
담당하는 망막 중심부의 노란색 부위
KIM’S RETINA CLINIC
최고의 의료진이 최선을 다하는 김이태안과 입니다.
황반변성
노화나 유전적 요인 등으로 인해 변성되는 것을 황반변성이라고 하는데, 황반에 변성이 생기면 기능이
떨어지면서 시력이 감소하며, 심한 경우 실명을 유발할 수 있는 질환입니다.

황반변성 주사 전
황반변성 주사 후

황반변성 자가진단
암슬러 격자 자가진단
아래와 같은 증상이 하나라도 있다면 가까운 병원에 내원하시길 바랍니다.
01
사물의 형태를 구별하기
어려워진다.
02
사물이 휘어지거나
찌그러져 보인다.
03
시야의 중심이 검거나
공백이 있다.
04
글을 읽을 때
글자에 공백이 생긴다.
05
색, 명암 구별이
어려워진다.
황반변성 치료
안저촬영 및 빛간섭단층촬영에서 보이는 건성 황반변성

망막에 드루젠이라는 지성 노폐물이 쌓이면 정상적으로 황반에 시상이
맺히는 것을 방해해 건성 황반변성으로 악화됩니다.
항산화제 복용, 금연, 자외선 노출 방지 등 악화를 최소화하는 예방법이 필요합니다.
안저촬영 및 빛간섭단층촬영에서 보이는 습성 황반변성

망막 아래 맥락막에서 새로운 혈관이 생겨 출혈이나 삼출물이 나오게 되면
습성 황반변성이 됩니다.
레이저 광응고술, 광역학요법 등을 이용한 치료가 필요합니다.
황반변성을 예방하기 위해서는 안구보호를 위한 선글라스 착용 및
규칙적인 운동을 통해 심혈관 질환을 예방하는 것도 중요합니다.
고혈압 체크
당뇨병 예방
체중 관리
식생활 개선
고지혈증 예방
금연